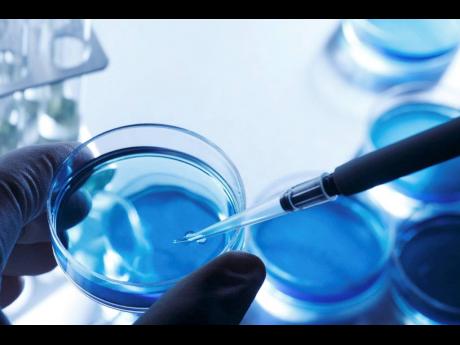

Poop being used to treat illnesses
Would you knowingly put someone's poop into your system if your life depended on it?
Jamaican scientist Dr Paul Brown says there is merit to a research being conducted in Europe by a scientist who has been stockpiling poo to help cure diseases.
Convinced that some bacteria in human excrement can be useful in the treatment of illnesses, Adrian Egil, a scientist at the University of Zurich in Switzerland, has been requesting frozen faeces from across the world that will allow him to create a vault of human microbiome. Stool samples from nations such as Ethiopia and Puerto Rico have reportedly been delivered to his lab.
Asked to comment on the poop's potential to cure diseases, Brown, a professor of molecular biology at The University of the West Indies (UWI), Mona, told THE WEEKEND STAR that the use of bacteria harvested from faeces has been proven to be useful in the treatment of C. diff bacteria.
He, noted, however that in Jamaica there is the likely to be a "rejection of the use of somebody's poo as treatment".
The US Centers for Disease Control and Prevention said that C. diff can be life-threatening. It says most cases of the infection that manifests in diarrhoea or inflammation of the colon, occur while persons are taking antibiotics or not long after they have completed a course of the drug.
Researchers have proven that when antibiotics kill off too many good bacteria in the digestive tract, faecal transplants can help replenish bacterial balance. The US Food and Drug Administration last month approved a faecal transplant therapy.
Scientists have been using poop in the treatment of C. diff, through a process known as faecal microbiota transplantation (FMT). Also known as stool transplantation or bacteriotherapy, FMT is a procedure in which stool is collected from a healthy donor and placed into the gastrointestinal tract of a patient.
Brown said that FMT is now accepted as an effective treatment for C-diff diarrhoea, with over 90 per cent efficacy. He said that human clinical trials are ongoing for the use of FMT in the treatment of ulcerative colitis, diabetes mellitus, metabolic syndrome, several cancers, and some neurologic diseases such as Parkinson's disease.
The UWI professor, who is also a council member of the American Society for Microbiology, however, noted that the transfer of live microorganisms from 'healthy' donors to sick patients has inherent risks. He suggested that it is not something Jamaica can consider at this time.
"Given the status of the technology and regulation, the occurrence of several deaths caused by FMT, and the likely rejection of the use of somebody's poo as treatment, I don't think that Jamaica would be ready for the application of FMT for the foreseeable future," Brown said.